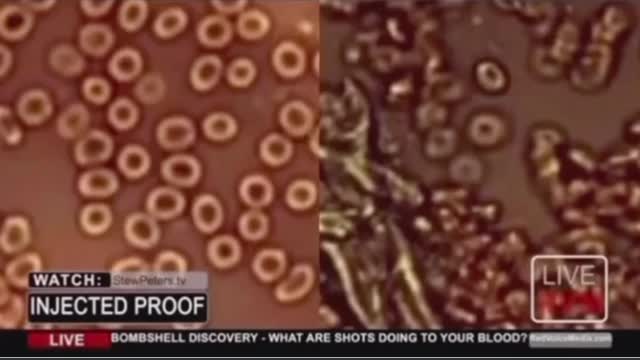
ENG vakcinetu cilveku asinis BLOOD after vaccine covid

Premium Only Content
This video is only available to Rumble Premium subscribers. Subscribe to
enjoy exclusive content and ad-free viewing.
ENG vakcinetu cilveku asinis BLOOD after vaccine covid
Loading comments...
-
 1:02:26
1:02:26
BonginoReport
4 hours agoDemocrat "Squad" Runs Cover For Somali Fraudsters - Nightly Scroll w/ Hayley Caronia (Ep.192)
34.5K43 -
 LIVE
LIVE
The Jimmy Dore Show
3 hours agoAaron Maté CONFRONTS Hillary Over Gaza! PCR Tests FAILED 86% of the Time! w/ Dr. Aaron Kheriaty
7,796 watching -
 LIVE
LIVE
Sen D Regon
2 hours agoTails of Iron Ep1 | The Day The Prince Stands
34 watching -
 LIVE
LIVE
There_Is_No_Presto
2 hours agoBed, Bath & Metroid Prime 4 : Beyond Pt 1
10 watching -
 17:55
17:55
MetatronHistory
2 days agoAncient Greece and The Sumerian Civilization Compared
2.37K -
 LIVE
LIVE
cosmicvandenim
5 hours agoCOSMIC VAN DENIM | ARC Raiders
20 watching -
 3:27:09
3:27:09
IronAngel26
4 hours ago $0.04 earnedBack after getting lunch for the baby and myself. Now we game HARD!! Pus New Emotes
1.28K -
 1:01:40
1:01:40
TheCrucible
4 hours agoThe Extravaganza! EP: 71 with Guest Co-Host Rob Noerr (12/08/25)
98.1K12 -
 2:02:02
2:02:02
Redacted News
5 hours agoThe EU is Collapsing and Elon Musk just went Nuclear on Brussels, Trump slams Zelensky | Redacted
131K71 -
 18:17
18:17
Stephen Gardner
4 hours agoYou WON’T Believe The GOOD NEWS Trump Just Got!!
39.7K27